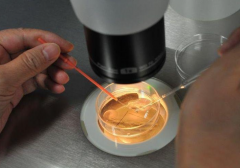
上海供卵试管医院全新排行榜曝光，教你如何精准挑选试管机构

助孕指南

-
 全球试管技术排名大揭秘:附带热门国家一览!
全球试管技术排名大揭秘:附带热门国家一览!近年来随着科技的不断发展,试管技术在全球范围内得到了广泛应用。一份最新的全球试管排名报告显示,目前美国、俄罗斯、印度等国家是全球试管领域的大国。 全球试管
作者:婷婷 131 发布时间:2026-04-14 -
上海供卵试管医院全新排行榜曝光,教你如何精准挑选试管机构
上海供卵试管医院全新排行榜曝光,教你如何精准挑选试管机构随着科技的不断发展,试管技术越来越成熟,成为许多不孕不育夫妇实现生育梦想的重要方式。然而在选择试管机构时,也需要考虑多方面因素,以确保治疗效果和安全性。本文将为您介
作者:婷婷 74 发布时间:2026-04-14 -
 试管失败率有多高?教你几招降低风险!
试管失败率有多高?教你几招降低风险!试管是指通过体外受精和移植的方式来达到怀孕的生殖技术,它的出现开辟了与其他生殖方式不同的途径,帮助许多家庭拥有了孩子,但是试管也有其失败的概率,这是不可避免的现
作者:木易 62 发布时间:2026-04-14 -
 试管之旅:从准备到成功的详细攻略,六大关键事项不可不知
试管之旅:从准备到成功的详细攻略,六大关键事项不可不知试管是一种被用来治疗不孕不育的技术,它可以帮助有不孕症的夫妻实现家庭梦想。试管技术的最新进展使得它不仅仅可以用于治疗不孕症,还可以用于预防遗传病或其他疾病,让有
作者:婷婷 94 发布时间:2026-04-14 -
 俄罗斯试管之旅:必须牢记的注意事项与潜在风险
俄罗斯试管之旅:必须牢记的注意事项与潜在风险随着科技的不断发展,试管手术已成为许多不孕夫妇的福音。然而,一些人担心去俄罗斯进行试管手术是否存在风险。那么真的有这样的风险吗?接下来我们请专家来为大家解答。 试管
作者:婷婷 126 发布时间:2026-04-14 -
 试管取精步骤:这些细节你不可不知!
试管取精步骤:这些细节你不可不知!近年来,试管技术已经成为解决不孕不育问题的重要手段之一,其中取精过程是试管技术中最关键的部分。试管取精过程是指将特定的精子与卵子结合在一起,以此达到受精的目
作者:木易 138 发布时间:2026-04-14 -
 泰国和日本试管技术大PK,看看哪个更适合你!
泰国和日本试管技术大PK,看看哪个更适合你!由于试管技术在近年来取得了较大的进步,越来越多的夫妻在考虑采取试管技术来治疗不孕不育症。目前,去泰国和去日本进行试管治疗是比较受欢迎的选择。那么去泰国日本试
作者:木易 144 发布时间:2026-04-14 -
 试管之旅启程:前期检查项目全攻略,详尽流程一文速览
试管之旅启程:前期检查项目全攻略,详尽流程一文速览试管是一种新型的辅助生殖技术,它可以帮助不孕不育的夫妻重获怀孕的机会,改善夫妻生育愿望。在试管技术中,患者需要接受试管前期检查项目,以确定是否有受精卵可供移
作者:wednesday 95 发布时间:2026-04-14 -
 试管促排期雌二醇偏低探秘,根源解析与高效应对策略汇总
试管促排期雌二醇偏低探秘,根源解析与高效应对策略汇总试管的第一步是促排,这是一个关键的时期,因为任何一处不当都会影响促排的成功率。其中一个重要的因素是雌二醇水平,即体内雌激素的水平。如果雌二醇水平过低,就会导致促排失
作者:wednesday 158 发布时间:2026-04-14 -
 试管促排黄金期:加速卵泡优质成长的秘诀与关键注意事项
试管促排黄金期:加速卵泡优质成长的秘诀与关键注意事项试管技术是一种较新的生育技术,它可以使不可怀孕的夫妻梦想实现,也可以帮助有生育问题的夫妻更快地怀孕。为了使这项技术有效,最重要的一步就是让卵泡长得快又好。因此要想让
作者:wednesday 111 发布时间:2026-04-14 -
 宫外孕后实现试管双胞胎的可能性大吗?成功生育全程步骤深度解析
宫外孕后实现试管双胞胎的可能性大吗?成功生育全程步骤深度解析宫外孕是一种危险的妇科疾病,会严重影响到女性的生殖健康。然而,在经历了宫外孕手术后,仍有许多女性希望能够顺利怀孕并且顺利分娩,这也是很多人选择试管的原因之一。下面我
作者:wednesday 150 发布时间:2026-04-14 -
 试管促排期间理想FSH值范围是多少?超标情况下的个性化治疗方案
试管促排期间理想FSH值范围是多少?超标情况下的个性化治疗方案FSH(即卵泡刺激素)是一种重要的性腺激素,它由下丘脑释放,在女性体内起着促进卵巢发育、卵泡发育和排卵的作用。它在男性体内也起着控制性腺功能的作用。试管受精过程中,通常需要用药
作者:wednesday 170 发布时间:2026-04-14
